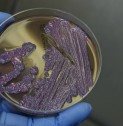

Aim:
The aim of the Closing the loop on life-threatening melioidosis infections: observational research informing clinical practice change and policy for adults with severe kidney disease study is to determine the efficacy and safety of prophylaxis with daily oral TMP/SXT for melioidosis in haemodialysis patients from the Top End during the wet season from November 2014 to April 2015.
Summary:
Territorians who need dialysis to manage severe kidney disease were among a very high risk group susceptible for melioidosis infections and related harms[1]. In response to this, we undertook this study.
Implications for policy and practice:
This practice has been successfully embedded in standard care in the Top-End of the Northern Territory.
Our research has found:
Melioidosis risk can be significantly minimized in this high risk group through a comprehensive strategy providing useful and meaningful information to clients and dialysis health care staff, along with the antibiotic prevention treatment.
Chief investigators:
- Jaqui Hughes
- William Majoni (Royal Darwin Hospital)
- Bart Currie
- Bianca Heron (Royal Darwin Hospital)
Start date:
September 2014
[1]
- Chalmers, R.M., Majoni, S.W., Ward, L., Perry, G.J., Jabbar, Z., Currie, B.J. (2014). Melioidosis and end-stage renal disease in tropical northern Australia. Kidney International, 86(5), 867-70.
- Jabbar, Z., Currie, B.J. (2013). Melioidosis and the kidney. Nephrology, 18(3),169-75.
- Majoni, S.W., Heron, B., Hughes, J.T. & Currie, B.J. (2016). Trimethoprim/sulfamethoxazole (TMP/SXT) prophylaxis to reduce rates of meliodosis in high risk haemodialysis patients in the Top End of Australia. Nephrology, 21(S2),118.
Funders:
- The 2016 Harry Christian Giese Research into Action Award.